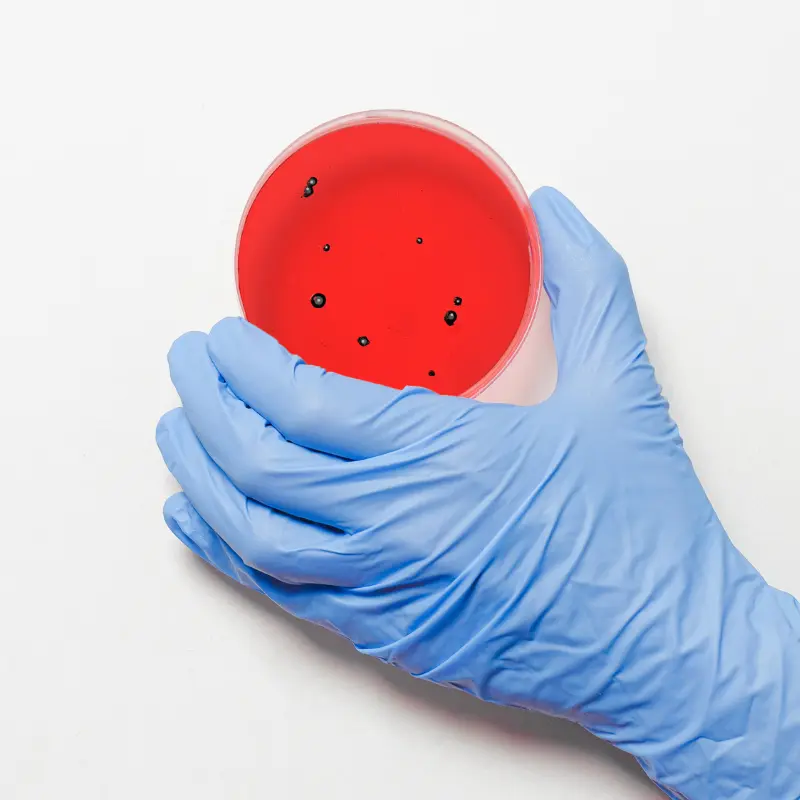

Advancing the future of medicine one day at a time.

Lorem ipsum dolor sit amet, consectetur adipiscing elit suspendisse.

Lorem ipsum dolor sit amet, consectetur adipiscing elit suspendisse.
We partner with leading manufacturers and healthcare providers to keep Oman’s supply of medicines and medical equipment reliable, compliant and patient-focused.




.svg)




.svg)




.svg)




.svg)




.svg)




.svg)




.svg)





Lorem ipsum dolor sit amet, consectetur adipiscing elit — sed do eiusmod tempor incididunt ut labore et dolore magna.
Get in touch today to learn more.